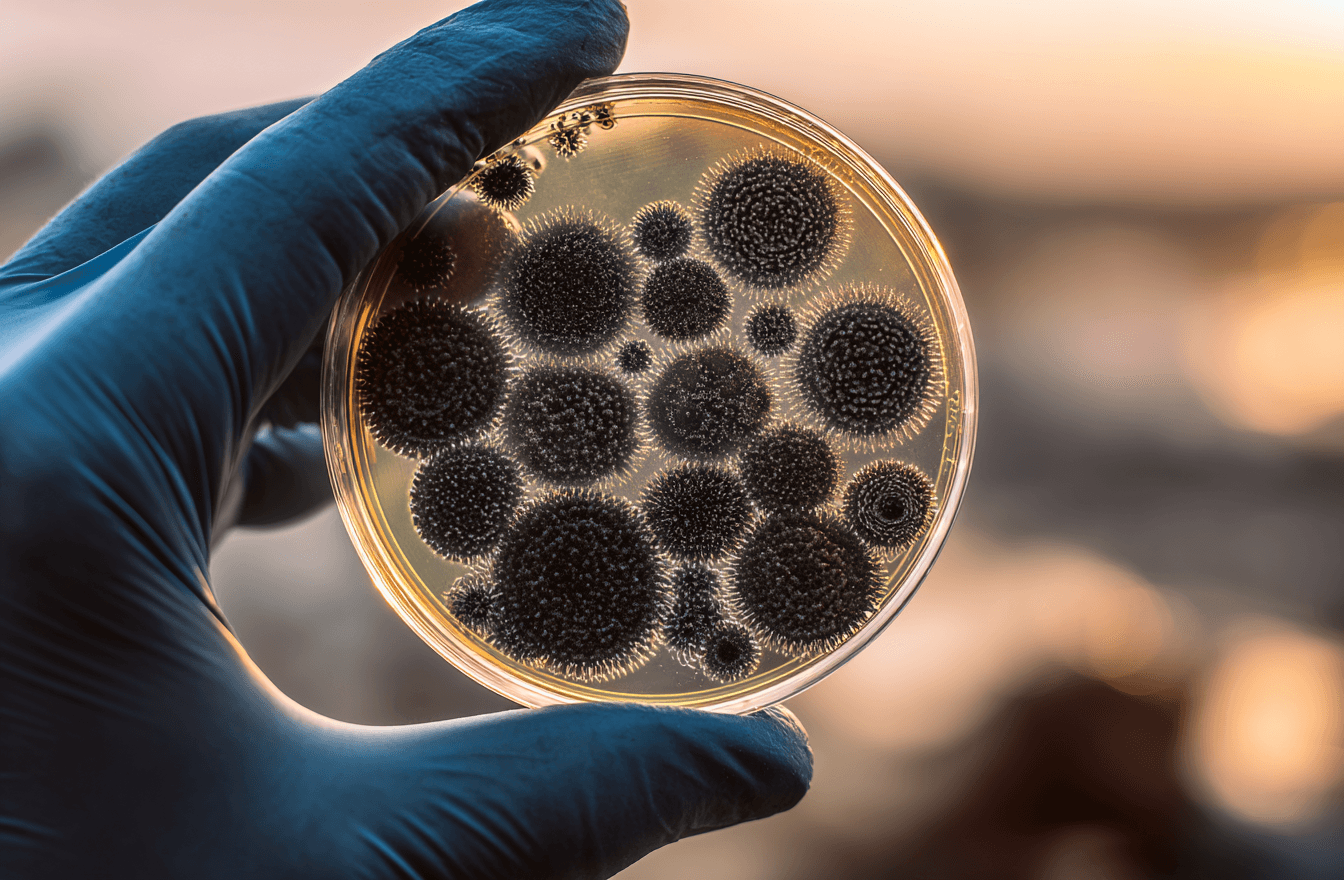
Service Image

Back to Services

Bioremediation & Dépollution
Bioremediation & Dépollution
Bioremediation & Dépollution
Solutions vertes pour la dépollution des sols et eaux
Solutions vertes pour la dépollution des sols et eaux
La bioremédiation utilise des microorganismes, plantes et enzymes pour dépolluer sols, eaux et sédiments. Cette méthode naturelle et durable élimine hydrocarbures, métaux lourds, solvants et autres contaminants, tout en valorisant vos sites et renforçant votre engagement environnemental. L'utilisation de ce procédé permet de: - réduire l'impact environnemental: Pas d’ingrédients chimiques nocifs, réduction des sous-produits dangereux - Coûts optimisés : Fréquemment plus économique que l’incinération ou la mise en décharge grâce à la dégradation in situ - Durabilité & acceptabilité : Respecte les écosystèmes e rassure les parties prenantes locales Les avantages clés pour vos projets: - Efficacité prouvée sur les hydrocarbures (fuites, choc pétrolier) et solvants chlorés - Réduction durable des contaminants à faibles concentrations à moindres frais - Reconstruction de sites – rendu des terrains réutilisables (agricoles, industriels ou naturels) - Image & conformité – renforcement de votre engagement RSE et anticipation des réglementations. Sans chimie agressive, sans solutions lourdes, nous dépolluons durablement les sites touchés par les hydrocarbures ou solvants. SOCADIS vous accompagne à chaque étape pour redonner un avenir à vos terrains.
La bioremédiation utilise des microorganismes, plantes et enzymes pour dépolluer sols, eaux et sédiments. Cette méthode naturelle et durable élimine hydrocarbures, métaux lourds, solvants et autres contaminants, tout en valorisant vos sites et renforçant votre engagement environnemental. L'utilisation de ce procédé permet de: - réduire l'impact environnemental: Pas d’ingrédients chimiques nocifs, réduction des sous-produits dangereux - Coûts optimisés : Fréquemment plus économique que l’incinération ou la mise en décharge grâce à la dégradation in situ - Durabilité & acceptabilité : Respecte les écosystèmes e rassure les parties prenantes locales Les avantages clés pour vos projets: - Efficacité prouvée sur les hydrocarbures (fuites, choc pétrolier) et solvants chlorés - Réduction durable des contaminants à faibles concentrations à moindres frais - Reconstruction de sites – rendu des terrains réutilisables (agricoles, industriels ou naturels) - Image & conformité – renforcement de votre engagement RSE et anticipation des réglementations. Sans chimie agressive, sans solutions lourdes, nous dépolluons durablement les sites touchés par les hydrocarbures ou solvants. SOCADIS vous accompagne à chaque étape pour redonner un avenir à vos terrains.


Contactez-nous
(+687) 27 03 08

Contactez-nous
socadis@socadis.nc
Pourquoi SOCADIS ?
Pourquoi SOCADIS ?
Pourquoi SOCADIS ?
Pourquoi nous choisir ?
Pourquoi nous choisir ?
Fiable, réactive et professionnelle, notre entreprise propose des solutions complètes pour la collecte, le conditionnement, le transport, l’export et le traitement des déchets dangereux.
Fiable, réactive et professionnelle, notre entreprise propose des solutions complètes pour la collecte, le conditionnement, le transport, l’export et le traitement des déchets dangereux.




Conformité réglementaire locale et internationale
L’entreprise maîtrise la législation spécifique à la Nouvelle-Calédonie et aux normes internationales (ADR, Bâle,Waigani, etc...), vous garantissant une gestion sans risque juridique.

Conformité réglementaire locale et internationale
L’entreprise maîtrise la législation spécifique à la Nouvelle-Calédonie et aux normes internationales (ADR, Bâle,Waigani, etc...), vous garantissant une gestion sans risque juridique.

Conformité réglementaire locale et internationale
L’entreprise maîtrise la législation spécifique à la Nouvelle-Calédonie et aux normes internationales (ADR, Bâle,Waigani, etc...), vous garantissant une gestion sans risque juridique.

Sécurité renforcée et traçabilité
Grâce à des procédures strictes, un matériel adapté et un personnel formé, SOCADIS assure la sécurisation totale des déchets dangereux tout au long de la chaîne logistique.

Sécurité renforcée et traçabilité
Grâce à des procédures strictes, un matériel adapté et un personnel formé, SOCADIS assure la sécurisation totale des déchets dangereux tout au long de la chaîne logistique.

Sécurité renforcée et traçabilité
Grâce à des procédures strictes, un matériel adapté et un personnel formé, SOCADIS assure la sécurisation totale des déchets dangereux tout au long de la chaîne logistique.

Adaptation aux contraintes géographiques insulaires
Basée en Nouvelle-Calédonie, l’entreprise optimise les opérations d’export maritime, prend en compte les réalités logistiques locales et agit avec réactivité sur tout le territoire.

Adaptation aux contraintes géographiques insulaires
Basée en Nouvelle-Calédonie, l’entreprise optimise les opérations d’export maritime, prend en compte les réalités logistiques locales et agit avec réactivité sur tout le territoire.

Adaptation aux contraintes géographiques insulaires
Basée en Nouvelle-Calédonie, l’entreprise optimise les opérations d’export maritime, prend en compte les réalités logistiques locales et agit avec réactivité sur tout le territoire.

Expertise technique spécialisée
Elle possède des compétences spécifiques en classification, conditionnement agréé (UN), échantillonnage, et assure une gestion sûre de substances complexes (produits chimiques, déchets médicaux, hydrocarbures, etc...).

Expertise technique spécialisée
Elle possède des compétences spécifiques en classification, conditionnement agréé (UN), échantillonnage, et assure une gestion sûre de substances complexes (produits chimiques, déchets médicaux, hydrocarbures, etc...).

Expertise technique spécialisée
Elle possède des compétences spécifiques en classification, conditionnement agréé (UN), échantillonnage, et assure une gestion sûre de substances complexes (produits chimiques, déchets médicaux, hydrocarbures, etc...).

Engagement environnemental fort
Une entreprise locale impliquée dans la préservation du territoire, avec des process visant à réduire l’empreinte carbone et valoriser les déchets exportés dans des filières certifiées.

Engagement environnemental fort
Une entreprise locale impliquée dans la préservation du territoire, avec des process visant à réduire l’empreinte carbone et valoriser les déchets exportés dans des filières certifiées.

Engagement environnemental fort
Une entreprise locale impliquée dans la préservation du territoire, avec des process visant à réduire l’empreinte carbone et valoriser les déchets exportés dans des filières certifiées.

Accompagnement personnalisé & proximité
Contrairement à des prestataires distants ou généralistes, l’entreprise offre un suivi sur-mesure, des audits sur site, et une vraie relation de confiance, adaptée aux besoins industriels calédoniens.

Accompagnement personnalisé & proximité
Contrairement à des prestataires distants ou généralistes, l’entreprise offre un suivi sur-mesure, des audits sur site, et une vraie relation de confiance, adaptée aux besoins industriels calédoniens.

Accompagnement personnalisé & proximité
Contrairement à des prestataires distants ou généralistes, l’entreprise offre un suivi sur-mesure, des audits sur site, et une vraie relation de confiance, adaptée aux besoins industriels calédoniens.
Questions & Réponses
Questions fréquemment posées

En quoi consiste la traçabilité des déchets entrant dans les filières TRECODEC ?
La traçabilité consiste à s’assurer que les déchets collectés dans les filières REP soient acheminés jusqu’au site de prétraitement puis exportés vers l’usine de traitement final. Un Bordereau de Suivi des Déchets est rempli par chacun des acteurs du processus de recyclage via notre plateforme DEMATREC.
Comment faire pour demander une collecte pour mes déchets REP ?
Pourquoi le montant de l’éco-participation varie selon les filières de déchets ?
Combien coûte notre prestation ?
Une autre question ?
D’autres questions ?
Besoin d’aide, d’informations ou un partenariat ? Contactez-nous, nous sommes à votre écoute !
Questions & Réponses
Frequently Asked Questions

En quoi consiste la traçabilité des déchets entrant dans les filières TRECODEC ?
La traçabilité consiste à s’assurer que les déchets collectés dans les filières REP soient acheminés jusqu’au site de prétraitement puis exportés vers l’usine de traitement final. Un Bordereau de Suivi des Déchets est rempli par chacun des acteurs du processus de recyclage via notre plateforme DEMATREC.
Comment faire pour demander une collecte pour mes déchets REP ?
Pourquoi le montant de l’éco-participation varie selon les filières de déchets ?
Combien coûte notre prestation ?
Une autre question ?
D’autres questions ?
Besoin d’aide, d’informations ou un partenariat ? Contactez-nous, nous sommes à votre écoute !
Questions & Réponses
Questions fréquemment posées

En quoi consiste la traçabilité des déchets entrant dans les filières TRECODEC ?
La traçabilité consiste à s’assurer que les déchets collectés dans les filières REP soient acheminés jusqu’au site de prétraitement puis exportés vers l’usine de traitement final. Un Bordereau de Suivi des Déchets est rempli par chacun des acteurs du processus de recyclage via notre plateforme DEMATREC.
Comment faire pour demander une collecte pour mes déchets REP ?
Pourquoi le montant de l’éco-participation varie selon les filières de déchets ?
Combien coûte notre prestation ?
Une autre question ?
D’autres questions ?
Besoin d’aide, d’informations ou un partenariat ? Contactez-nous, nous sommes à votre écoute !

